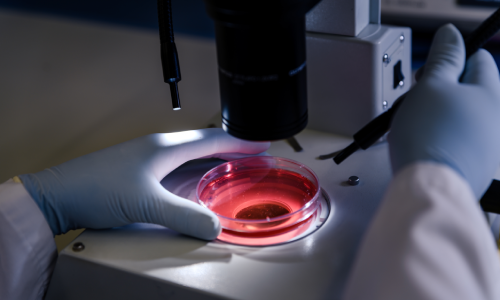

Facilities Available

In Vitro Fertilization

Ovulation Induction

Oocyte Freezing

Blastocyst Culture

Embryo Donation

Semen Morphology

Intrauterine Insemination
Laser-Assisted Hatching
Surgical Treatments
Pre- implantation genetic screening refers to genetic profiling of embryos prior to implantation. It is an adjunct to Assisted Reproductive Technology and requires IVF to obtain oocytes or embryos for evaluation. It is useful for individuals which include carrier for sex-linked genetic disorder, carrier for single gene disorders like Thalassemia, Cystic fibrosis, Huntington’s Chorea, Sickle Cell Disease, those with chromosomal disorder, women over 35 years and over, women experiencing recurrent pregnancy loss and women with more than one failed infertility treatment or repeated implantation failure We are also offer complete range of surgical treatment including:-

Enter at least 2 characters...
Enter at least 2 characters...
Enter at least 2 characters...
Enter at least 2 characters...
Enter at least 2 characters...






.webp)


.webp)